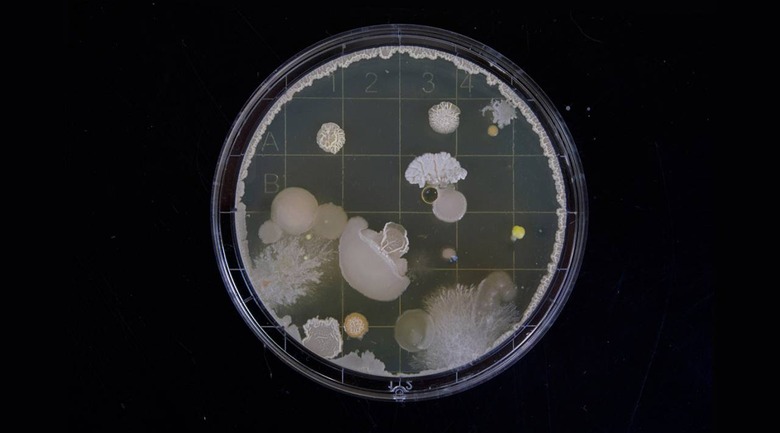

Artificial Intelligence Finds Compound That Can Destroy Superbugs
Antibiotic-resistant 'superbugs' are a growing concern, spurring efforts to develop new types of treatments that can eradicate these bacteria. Here to help is a machine-learning algorithm developed by researchers with MIT; it identified a new compound that can destroy several varieties of antibiotic-resistant superbugs, among them being certain bacteria that are now resistant to all available antibiotics.
The AI is described as a computer model that was fed more than 100,000,000 chemical compounds over a number of days. The system sorted through these options, ultimately finding compounds that are capable of destroying multiple superbugs. The results demonstrate the ways in which machine learning can help humans process vast amounts of data and pull useful information from it, all at speeds considerably faster than human-based processing.
'Our approach revealed this amazing molecule which is arguably one of the most powerful antibiotics that has been discovered,' according to MIT Termeer Professor of Medical Engineering James Collins. Joining it are other 'promising antibiotic candidates' that will be tested to determine whether they, too, can help combat the growing superbug problem.
This isn't the first time artificial intelligence has been tapped to process large amounts of information in order to find new arrangements of existing things. For example, the spice company McCormick has used IBM's AI technology to develop new spice combinations for various meals.
The same AI tech has also been used to create entirely new fragrances, as well, based on existing base scents. That work is being done by Philyra, a series of machine-learning algorithms capable of sorting through thousands of raw fragrances to figure out which complement each other and new arrangements that work well together.